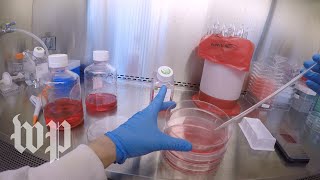

Inside the race to find a coronavirus vaccine and treatment video
Online izle ve mp4 mp3 formatlarinda yukle
Videonun muddeti: 3:32
Inside the race to find a coronavirus vaccine and treatment videosu mp4 ve mp3 yuklemek ucun hazirdir
Diqqet! Siz Mp4 yukle ve ya Mp3 yukle duymesine basdiqdan sonra eger sistem sizi reklam sehifesine atarsa o zaman derhal geri qayidib emeliyyati tekrar edin ve faylin yuklemek ucun hazir olmasini gozleyin
Videodan Mp4 Yukle
Videodan Mp3 Yukle-1
Videodan Mp3 Yukle-2
Oxshar Axtarishlar
Inside the race to find a coronavirus vaccine and treatment
Inside the race to find a coronavirus vaccine: A look at human trials and revolutionary approaches
Virus Update: The Race to Find a Vaccine for Covid-19
Inside The Race To Find A Vaccine | Frontrunner | Forbes
Inside the race for a COVID-19 vaccine: Part 1
The Race To Find A Vaccine | Inside The Outbreak | Associated Press
The Race to Develop a Coronavirus Treatment in 60 Days
Treatments, vaccines and testing: The latest developments in the fight against coronavirus
Race to find COVID-19 vaccine intensifying l ABC News
Video Mp4 Mp3Azwap.Biz
Azwap.Biz 2021-2023